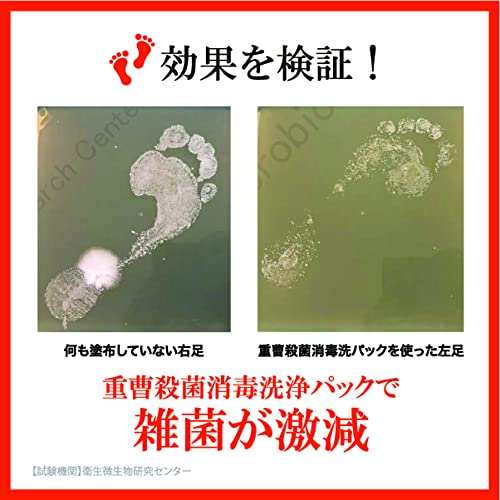
main

販売情報
画面をスクロールすると販売情報が更新されます。
最終更新:
最安値ショップ
最安値ショッピングサイト
実質価格ランキング
商品情報






商品説明はありません
| JANコード | 4533213677548 |
|---|---|
| 高さ | 4.6cm |
| 長さ | 4.6cm |
| 幅 | 18.5cm |
| メーカー | リベルタ |
| ブランド | ベビーフット (Baby Foot) |
画面をスクロールすると販売情報が更新されます。

商品説明はありません
| JANコード | 4533213677548 |
|---|---|
| 高さ | 4.6cm |
| 長さ | 4.6cm |
| 幅 | 18.5cm |
| メーカー | リベルタ |
| ブランド | ベビーフット (Baby Foot) |